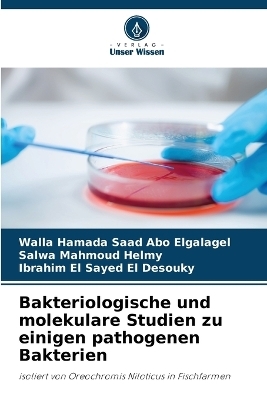
Bakteriologische und molekulare Studien zu einigen pathogenen Bakterien - Walla Hamada Saad Abo Elgalagel, Salwa Mahmoud Helmy, Ibrahim El Sayed El Desouky

Bakteriologische und molekulare Studien zu einigen pathogenen Bakterien
Seiten
2024
Verlag Unser Wissen
978-620-8-36551-6 (ISBN)
Verlag Unser Wissen
978-620-8-36551-6 (ISBN)
- Titel nicht im Sortiment
- Artikel merken
Bakterielle Krankheiten gehören zu den wichtigsten Ursachen für Verluste bei Fischbeständen. Ein umfassendes Verständnis der ätiologischen Erreger, der Pathogenese, der Biochemie, der Antigenität und der Wechselbeziehung zwischen Stress- und Umweltfaktoren ist für eine erfolgreiche Bewirtschaftung und Kontrolle unerlässlich. Andererseits gilt der Nil-Tilapia (Orechromis niloticus) als der am häufigsten gezüchtete Süßwasserfisch der Welt. Er hat seit den Tagen der alten Ägypter einen Beitrag zur weltweiten Aquakultur geleistet und ist nach wie vor eine der wichtigsten Süßwasserfischarten, die gezüchtet werden.
Walla Hamada Saad, B.V.Sc, Kafrelsheikh University, 2010, Diploma of Microbiology& M.V.Sc Bacteriology, Mycology & Immunology, Registered for PhD a staff Member of Central Diagnostic and Research Lab. für Fisch-, Geflügel- und Tierkrankheiten, Fakultät für Veterinärmedizin der Kafrelsheikh Universität.
| Erscheinungsdatum | 13.12.2024 |
|---|---|
| Sprache | deutsch |
| Maße | 152 x 229 mm |
| Gewicht | 118 g |
| Themenwelt | Veterinärmedizin |
| Schlagworte | bakteriologische und molekulare Studien • Fischzuchtbetriebe • Oreochromis niloticus • pathogene Bakterien |
| ISBN-10 | 620-8-36551-1 / 6208365511 |
| ISBN-13 | 978-620-8-36551-6 / 9786208365516 |
| Zustand | Neuware |
| Informationen gemäß Produktsicherheitsverordnung (GPSR) | |
| Haben Sie eine Frage zum Produkt? |
Mehr entdecken
aus dem Bereich
aus dem Bereich
Ein Handbuch für Tiermedizinische Fachangestellte
Buch | Softcover (2025)
Lehmanns Media (Verlag)
CHF 23,70
Buch | Hardcover (2025)
Schlütersche (Verlag)
CHF 124,60
Ein Ratgeber aus der Großtierpraxis
Buch | Hardcover (2025)
Stocker (Verlag)
CHF 25,20


